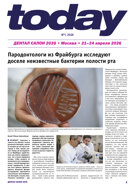
today Dental Salon Moscow April 21–24, 2026

E-papers
E-paper editions are exact digital copies of the DTI print publications. Readers can search and navigate through the e-paper, as well as download and print pages to read offline. In order to promote wide dissemination to our international readership, access to most e-papers is free.
Dental Tribunes
Dental Tribune is an independent publication and the largest global dental newspaper. It is a trusted source of news and information in the dental community and reaches more than 650,000 dental professionals around the world.
Latest Issues
DT Supplements
The Dental Tribune supplements were developed in response to increasing specialisation in dentistry. They have a clinical approach and feature case reports by general practitioners and specialists from around the globe.
Latest Issues
CE Magazines
The continuing education magazines represent the premium segment of DTI’s portfolio and offer a combination of clinical cases, scientific articles, interviews and product reports. The magazines present the most significant developments in the respective fields and are aimed at both specialists and general practitioners.Access to CE magazine editions published in the last two years require subscription. Older editions have immediate access.
Latest Issues
IADS
As official Media Partner of the International Association of Dental Students, DTI is featuring its official member publication, the IADS Magazine, on its platform since 2017.
Latest Issues



 Brazil / Brasil
Brazil / Brasil
 Canada / Canada
Canada / Canada
 Latin America / Latinoamérica
Latin America / Latinoamérica
 USA / USA
USA / USA
 Austria / Österreich
Austria / Österreich
 Bosnia and Herzegovina / Босна и Херцеговина
Bosnia and Herzegovina / Босна и Херцеговина
 Bulgaria / България
Bulgaria / България
 Croatia / Hrvatska
Croatia / Hrvatska
 Czech Republic & Slovakia / Česká republika & Slovensko
Czech Republic & Slovakia / Česká republika & Slovensko
 France / France
France / France
 Germany / Deutschland
Germany / Deutschland
 Greece / ΕΛΛΑΔΑ
Greece / ΕΛΛΑΔΑ
 Hungary / Hungary
Hungary / Hungary
 Italy / Italia
Italy / Italia
 Netherlands / Nederland
Netherlands / Nederland
 Nordic / Nordic
Nordic / Nordic
 Poland / Polska
Poland / Polska
 Portugal / Portugal
Portugal / Portugal
 Romania & Moldova / România & Moldova
Romania & Moldova / România & Moldova
 Slovenia / Slovenija
Slovenia / Slovenija
 Serbia & Montenegro / Србија и Црна Гора
Serbia & Montenegro / Србија и Црна Гора
 Spain / España
Spain / España
 Switzerland / Schweiz
Switzerland / Schweiz
 Turkey / Türkiye
Turkey / Türkiye
 UK & Ireland / UK & Ireland
UK & Ireland / UK & Ireland
 China / 中国
China / 中国
 India / भारत गणराज्य
India / भारत गणराज्य
 Pakistan / Pākistān
Pakistan / Pākistān
 Vietnam / Việt Nam
Vietnam / Việt Nam
 ASEAN / ASEAN
ASEAN / ASEAN
 Israel / מְדִינַת יִשְׂרָאֵל
Israel / מְדִינַת יִשְׂרָאֵל
 Algeria, Morocco & Tunisia / الجزائر والمغرب وتونس
Algeria, Morocco & Tunisia / الجزائر والمغرب وتونس
 Middle East / Middle East
Middle East / Middle East